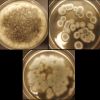

Post Overview
-
Expression
9 years ago +5 5 0
+5 5 0Artist Creates Ocean Treasures from the Sea's Materials
Canadian artist Debra Bernier creates amazing sculptures using shells and rotting driftwood she discovers from the ocean.
-
Video/Audio
9 years ago +5 5 0
+5 5 0A Cure for Wellness Trailer 2017
An ambitious young executive is sent to retrieve his company's CEO from an idyllic but mysterious "wellness center" at a remote location in the Swiss Alps but soon suspects that the spa's miraculous treatments are not what they se ...
-
Analysis
9 years ago +26 26 0
+26 26 0How blockchain is transforming business models
In this era of disruption, it’s absolutely necessary to redefine business models and archetypes as a whole. Enter, blockchain.
-
Expression
9 years ago +5 5 0
+5 5 0Stunning photos reveal the natural beauty in science
The exhibition, supported by technology giant Siemens, will be showcased for five weeks at the Crystal in the Royal Victoria Docks, London from September 14 before going on a UK tour.
-
Current Event
9 years ago +28 28 0
+28 28 0Body heat-harvesting wearable ups electricity generation efficiency
Kinetic energy from movement has been harnessed to charge batteries, and thermoelectric generators have powered wearable devices. Now researchers at NCSU have created a new wearable prototype that's lightweight, comfortable and much more efficie ...
-
Analysis
9 years ago +25 25 0
+25 25 0Anthrobotics: Where The Human Ends and the Robot Begins
The Anthrobotics Cluster seeks to start conversations (and answer questions) regarding some of the biggest topics in AI research. Here, Luis de Miranda, one of the founders, discusses anthrobots and the relationship between humans and machines.
-
Video/Audio
9 years ago +2 2 0
+2 2 0Silent Hopes: Documentary Film About Long Neck Karen People
The "Silent Hopes" is about Long Neck Karen people who are living in Mae Hong Son, the Northern Party of Thailand. Long Neck Karen are also called "Padaung" People.
-
Current Event
9 years ago +3 4 1
+3 4 1A 'second Earth' has been discovered
A group of global researchers made the discovery using the European Southern Observatory telescopes in Chile. They have named the exciting new world Proxima b.
-
Expression
9 years ago +15 15 0
+15 15 010 Beautiful Medieval Dutch Castles
The Netherlands has some pretty impressive medieval castles. Most of these Dutch castles are not world-renowned, nevertheless they are the witness of the glorious history of the country.
-
Current Event
9 years ago +7 7 0
+7 7 0Postage stamp-sized device can disinfect water in minutes
You only need to drop it in a container of water and leave it for around 20 minutes under the sun.
-
Current Event
9 years ago +33 33 0
+33 33 0Fungi recycle rechargeable lithium-ion batteries
Although rechargeable batteries in smartphones, cars and tablets can be charged again and again, they don't last forever. Old batteries often wind up in landfills or incinerators, potentially harming the environment. And valuable materials remai ...
0 comment(s) via phys.org -
Current Event
9 years ago +6 6 0
+6 6 0Samsung creates an image processor using IBM’s brain-chips
IBM’s been busy. A couple weeks back they unveiled a new line of neural computing chips that try to mimic the kinds of connections found in the brain. It could unleash incredible new leaps in parallel computing and revolutionize artificial intelligen ...
-
Current Event
9 years ago +2 2 0
+2 2 0Researchers develop a low-power always-on camera with gesture recognition
Smart devices that wake up with voice commands have gained popularity in recent years, and now researchers at Georgia Institute of Technology have taken it one step farther: an always-on camera.
0 comment(s) via phys.org -
Video/Audio
9 years ago +7 7 0
+7 7 0Movie Scenes That Were Nailed On The FIRST Take
Here are 10 famous movies scenes that only took one try to get right!
-
Expression
9 years ago +21 21 0
+21 21 0Rock Formation Image, California
Birds gather on a popular rock formation at Natural Bridges State Beach in Santa Cruz, California.
-
Expression
9 years ago +25 25 0 x 1
+25 25 0 x 1Bangladeshi Aviator Shoots Stunning Aerial Photos of His Green Country
Bangladeshi Air Force pilot Shamim Shorif Susom, a passionate photographer, has been taking advantage of his profession and capturing breathtaking bird’s-eye photos of the lush green landscape and waterways of his homeland from above.
-
Analysis
9 years ago +29 29 0
+29 29 0Traveling to Mars with immortal plasma rockets
Getting to Mars with current rocket technology will use massive amounts of fuel to move very small cargoes. There is a more fuel-efficient way.
-
Current Event
9 years ago +17 17 0
+17 17 0China's Hybrid Spaceplane Could Reset the 21st Century Space Race
The China Aerospace Science and Technology Corporation is beginning advanced research of such a spaceplane, which would be a high tech, more efficient successor to the retired Space Shuttle, with hybrid combined cycle engines that can takeoff from an ...
-
Image
9 years ago +2 2 0
+2 2 0Over 242 Million Years Old Dino
Partial skeleton fossil of a dinosaur that lived 242–247.2 million years ago, discovered in Guizhou, China
-
Video/Audio
9 years ago +22 22 0 x 1
+22 22 0 x 1Balkans Triangle
A road trip along the coast.




















